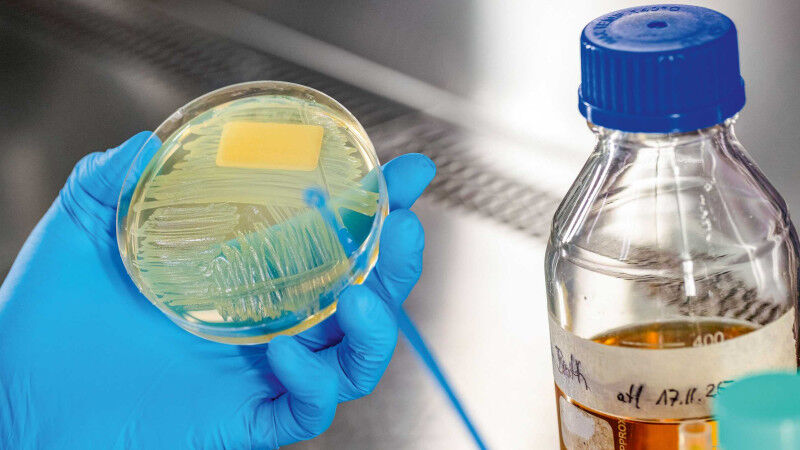

As dangerous microbes grow harder to control, researchers are exploring new ways to neutralise them using light-activated nanomaterials.
Wick and his lab have been grappling with questions of this nature for more than two decades. As a lecturer - and, as of 2023, adjunct professor - at the Department of Health Sciences and Technology, he maintains strong ties to ETH Zurich. One issue that particularly concerns him is the increasing resistance to antibiotics. "We urgently need new ways of treating and preventing infections," he explains. "With the antibiotics currently available, there are more and more pathogens that we can no longer control."
Wick’s lab is part of Health, one of four research focus areas at Empa. Projects here include the development of nanomaterials with antimicrobial properties - materials that destroy bacteria and viruses. Looking ahead, these materials could act as coatings for catheters, for example, to prevent microbes from taking hold. Likewise, dressings treated in this way would help wounds heal by keeping infections at bay.
Ultra-thin coatings
Nanomaterials have already found their way into medicine - those based on silver, copper or titanium dioxide, for example. Yet these metal-based materials have their drawbacks: some trigger allergic reactions, while others are effective against bacteria but do little to stop viruses. In response, the Nanomaterials in Health Lab is developing a new generation of materials designed to overcome these limitations. Backed by an EU grant, Wick brought chemist Giacomo Reina on board as project lead in 2023. Reina immediately set about identifying the building blocks for this new class of antimicrobial nanomaterials.
A major source of inspiration came from a research partner in the Czech Republic. A team from Palacký University Olomouc had come up with a material based on graphene - a carbon allotrope made up of a single layer of atoms. Reina immediately recognised its medical potential. What followed was a complex quest to turn this material into a weapon against harmful microbes. "We need nanomaterials to be not only antimicrobial," Reina explains, "but also tissue-compatible, environmentally friendly and stable."
The lab’s first candidate is based on graphene oxide embedded in polyvinyl alcohol, a plastic used in the food industry. Reina lifts a small glass slide that bears a coating undetectable to the human eye. "Our nanomaterial is ultra-thin and perfectly transparent," he explains. "That means it can be applied invisibly to a variety of medical equipment." To date, Reina has synthesised four different materials, each designed to further refine the desired properties. "As far as we know," he adds, "these are the first antimicrobial coatings to be based on graphene acid."
Through the skin
Many nanomaterials boast another striking feature: their antimicrobial power only kicks in when they are exposed to light. In the past, Wick’s lab has helped develop materials that are antibacterial by nature, without needing to be light-activated - a property that comes in handy for hospital curtains. For other applications, however, light activation is a real plus. "The antimicrobial effect can be precisely controlled: switched on and off, or dialled up and down with just the right amount of light energy," Reina explains.

To provide this energy, the team in St Gallen is initially working with near-infrared lamps, as used in hospitals for pain therapy. In the laboratory, Reina and doctoral candidate Paula Bürgisser don their protective glasses in preparation for the coming experiment. Bathed in yellow-orange light, small vials of the nanomaterial are heated to around 44 degrees Celsius.
Two things happen here: part of the effect comes from the heat, which weakens the microbes; more importantly, however, the light triggers a chemical reaction between the nanomaterial and oxygen in the air. This produces oxygen radicals: highly reactive molecules that damage the surface of the bacteria, either rendering them inactive or, in an ideal scenario, permanently neutralising them.
Infrared light comes with another advantage: it can penetrate body tissue by up to two centimetres, making it ideal for activating the antimicrobial coating of an implant beneath the skin.
Wick watches his team, clearly enchanted by the beauty of the process. "Isn’t it wonderful?" he says, his eyes lighting up. "We’re using physical energy to kick-start a chemical reaction with a real biological impact!"
Spotlight on hospital bugs
To see the proof that this idea actually works, we head one floor up in the Empa building to the Biointerfaces Lab, where these novel materials are being assessed in a biosafety facility. Do they really have antimicrobial properties? The team pits them against two dangerous and often drug-resistant hospital bugs, plus a virus. The first of the four materials has returned impressive results, eliminating almost 100 percent of one bacterial strain and around 91 percent of the other. That puts it well ahead of the silver-based coatings currently in use.
In another part of the lab, cultured skin cells are used to determine whether the nanomaterials cause any side effects - a fear that, so far, appears unfounded. Nor is there any sign of microbes developing resistance. But might not the 44 degrees Celsius - higher than a raging fever - be a cause for concern? Don’t body proteins begin to break down in that kind of heat? Wick’s answer is reassuring: the effect is so localised that tissue damage remains minimal, and the tissue fully regenerates once the treatment is over.
Safer dental implants
The proof-of-concept phase has been successfully concluded - the team has shown that the idea works. Yet Wick is quick to caution that the journey has only just begun. The big challenge now is to engineer different chemical formulations and types of lighting so as to fine-tune the material’s antimicrobial power for specific applications. Replace the infrared lamps with lasers, for example, and the nanomaterial can be activated with surgical precision. Then there’s the ultimate test: will it work inside the human body, where microbes often cluster in biofilms, which provide added protection against threats like antibiotics?
For their first real-world medical application, the team - backed by two foundations - has turned to dentistry. Dental implants can lead to serious infections, which in certain cases spread to the jawbone or even the whole body. Bürgisser’s dissertation, which she began in summer 2025, is investigating how nanomaterials might remedy these issues.
Having already worked at Wick’s lab as an Excellence Scholarship recipient during her Master’s in Health Sciences and Technology at ETH Zurich, she is now conducting her doctoral research under the supervision of Professor Roland Jung from the University of Zurich’s Center for Dental Medicine. Her project therefore sees her commuting between the two locations - developing nanomaterials in St Gallen and running antimicrobial tests in Zurich.
Permanently reactivatable
The concept is elegantly simple. When a patient receives a dental implant, the upper portion in contact with the gingiva is coated with a nanomaterial. Once the implant is in place, light is applied to eliminate any surface microbes. This treatment can be repeated at routine check-ups - or if an infection flares up.Tests so far show that the effect does not wear off and that the material can be repeatedly reactivated without losing its antimicrobial properties, Reina explains.
If all goes to plan, the team hopes to bring a private sector partner on board within the next three to four years for the next big step: clinical trials. Even then, Wick cautions, it could be another 10 to 15 years before the technology finds its way into everyday patient care.
Other medical applications are already on the team’s radar. "Nanomaterials can make a real difference in medicine," says Wick. "And we’re at the very beginning of this journey - basic research continues to deliver new findings." Alongside the fight against viruses and drug-resistant bacteria, he points to the development of ultrasensitive sensors based on nanomaterials and therapies to treat diseases like cancer. Right now, on the edge of St Gallen, innovations are emerging that might one day impact medical science around the globe.



